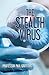
The Stealth Virus by Prof Paul D Griffiths (2012-09-23)

The Stealth Virus > Editions
by Paul Griffiths First published September 23rd 2012
Published September 23rd 2012
by CreateSpace Independent Publishing Platform
1, Paperback, 234 pages
Published October 2nd 2012
by CreateSpace Independent Publishing Platform
Kindle Edition, 235 pages
Published January 1st 2012
by CreateSpace Independent Publishing Platform
Paperback, 0 pages
Published
by CreateSpace Independent Publishing Platform
Paperback, 0 pages



![The Stealth Virus [PAPERBACK] [2012] [By Prof Paul D Griffiths]](https://i.gr-assets.com/images/S/compressed.photo.goodreads.com/books/1699937580l/164658324._SX50_.jpg)